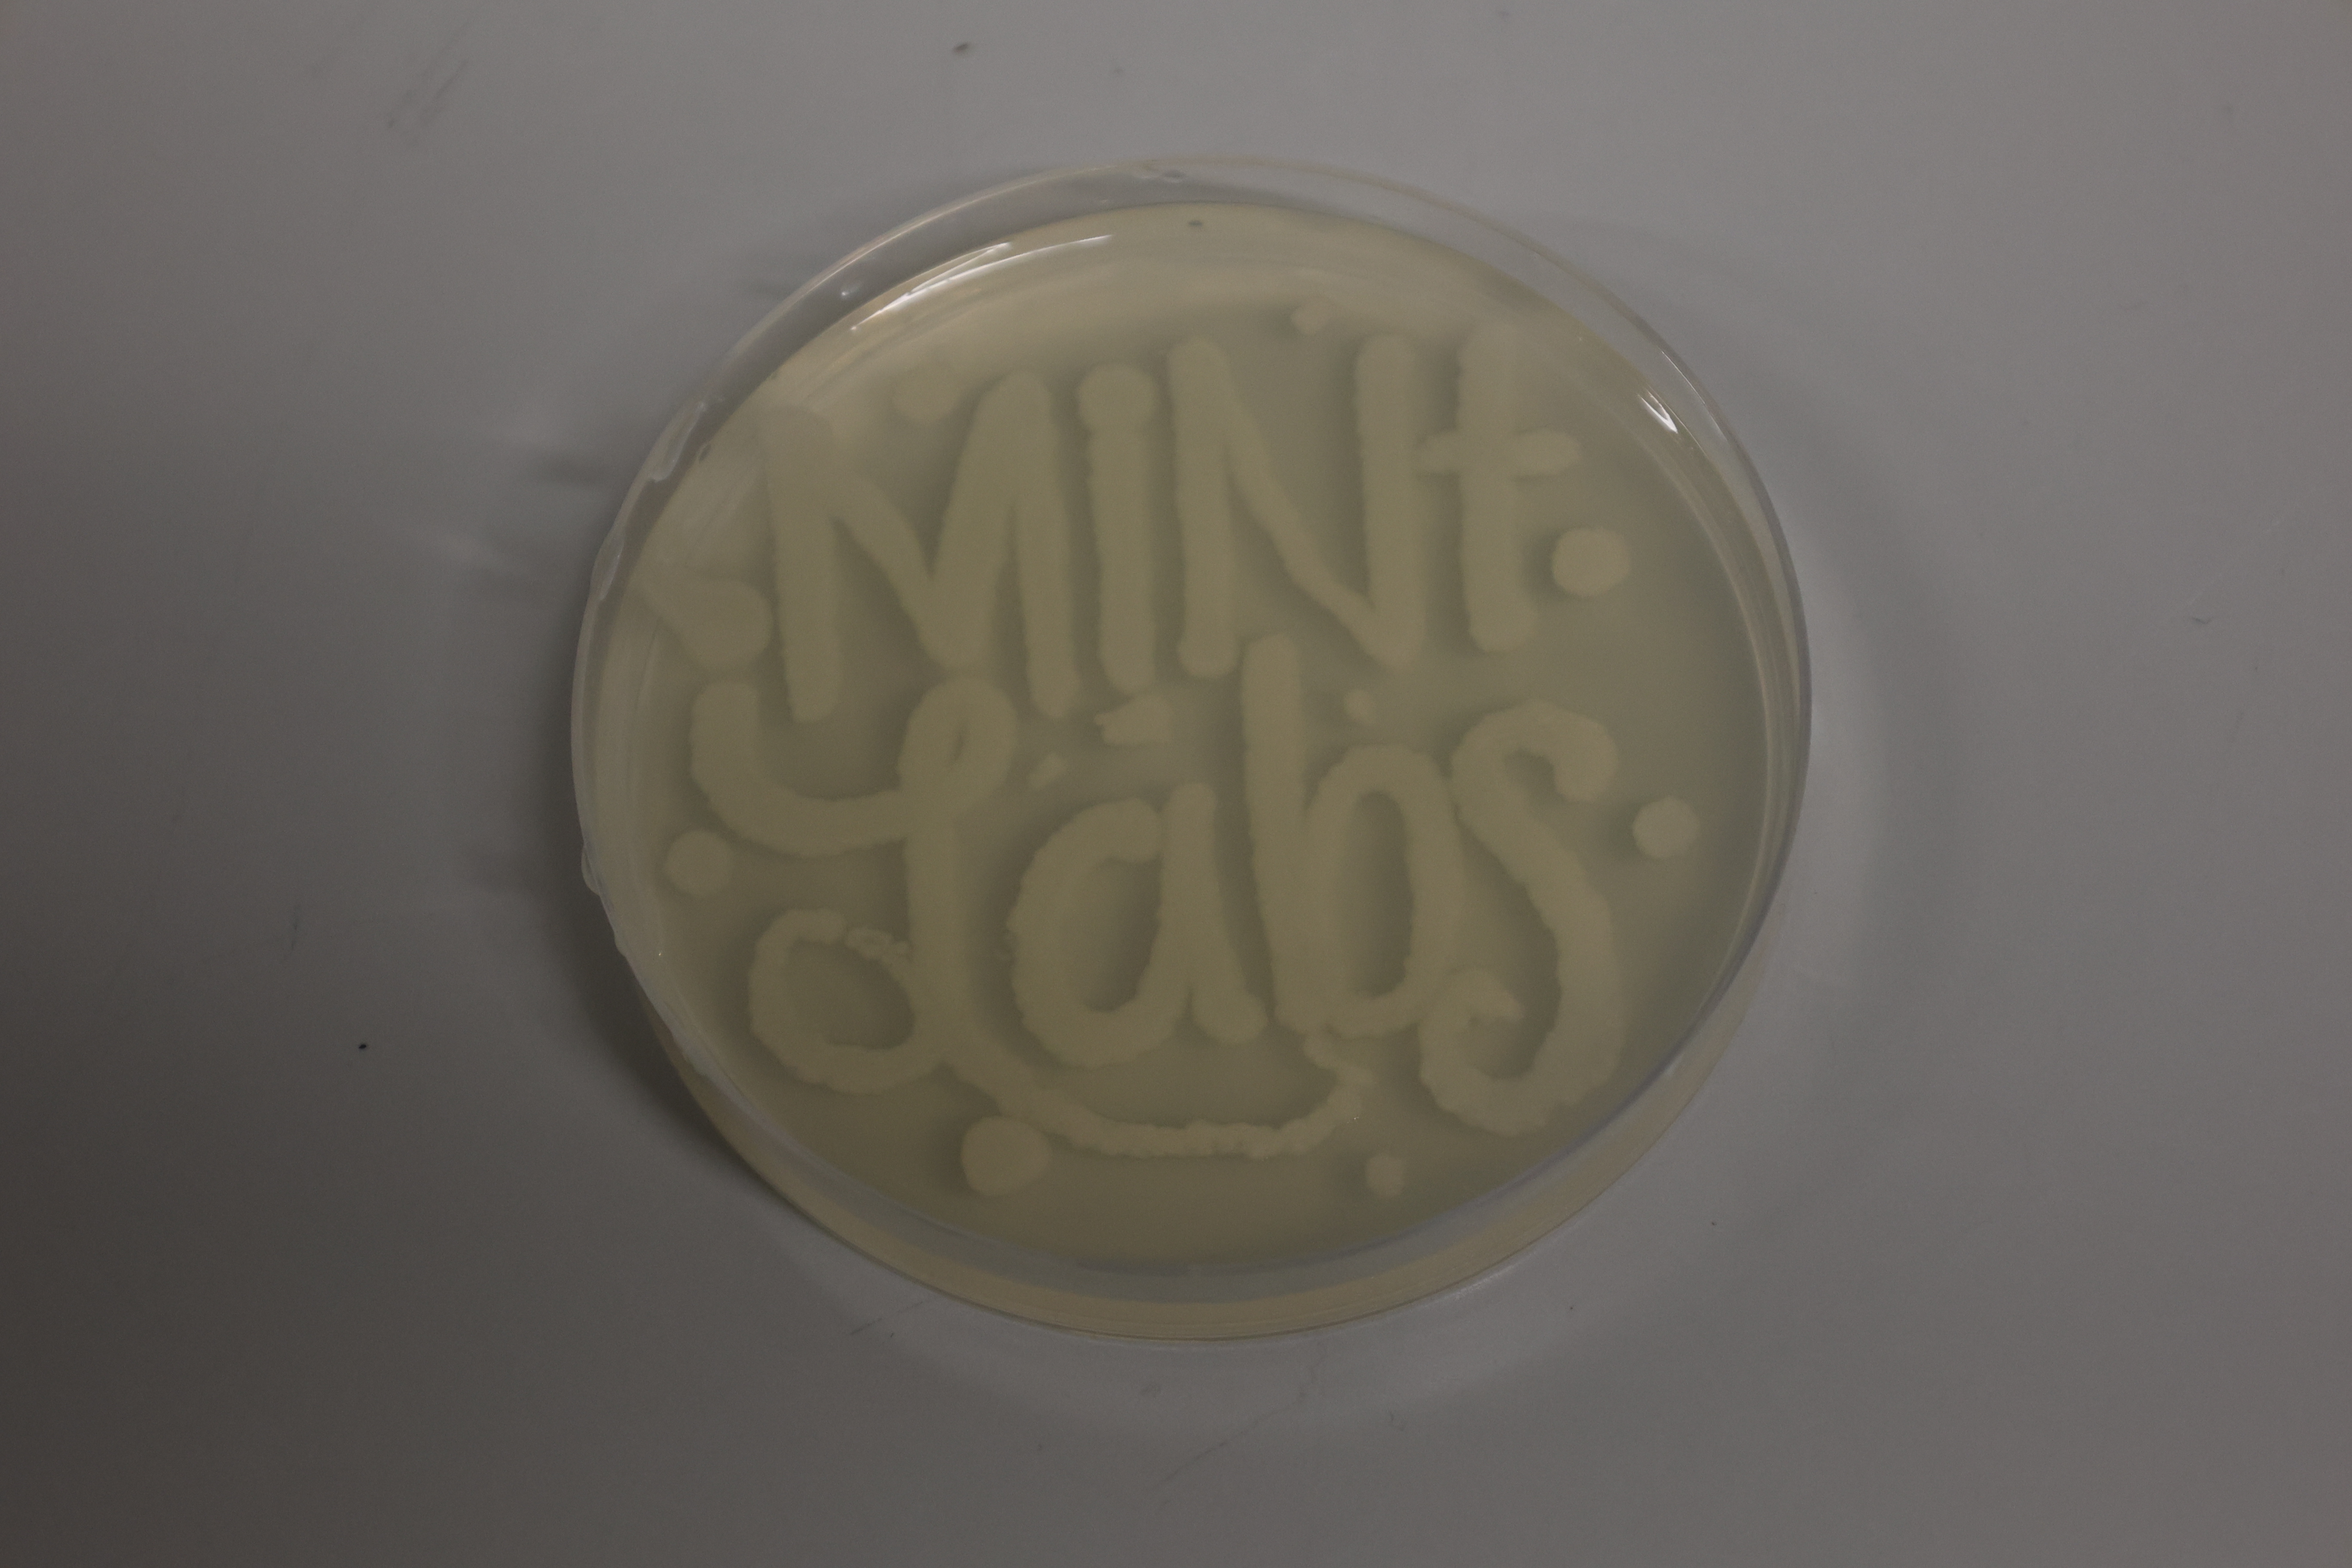

Public Relations
The PR group has several projects where you can get involved:
Project "Schulbesuch" / school visits
With the project "Schulbesuch" / school visits, we bring science to schools, motivating young people to start a career in science with simple yet fascinating experiments. Experiments feature, among others, DNA isolation, PCR and gel electrophoresis.
2-3 PhD students will be in charge of preparing and supervising experiments. Materials and machines are provided by RIGeL/university and have to be brought to the school, where experiments should be carried out in a suitable environment.
Schools should apply for a date. Experiments are then individually planned.
 |
 |
 |
Project "MINT-Labs"
We participate in the MINT-Labs e.V. in the RUBINA House (at the TechCampus Regensburg) with various projects, such as
yeast,
luminous bacteria,
speed dating, etc.
and supervise school classes on site.
 |
 |
 |
 |
|
 |
 |
 |
 |
Projects "Girl's Day/ Boy's Day", "Nacht.Schafft.Wissen" etc.
We organize open days at the UR as part of events such as Nacht.Schafft.Wissen or Boy‘s/Girl‘s Days etc.
 |
 |
 |
 |
 |
 |
Our group members
Adlmanninger Elena - Section CBB (since October 2025)
BENZAL--MAZUY Jeanne - BIOMEDIGS (since September 2024)
Brandl Tirza - Section CBB (since April 2023)
Dobrowitsch Moritz - Section CBB (since November 2023)
Gringel Iris - Section CBB (since October 2025)
Hermann Timo - Section CBB (since July 2025)
Schüler Jan - Section Biomed (speaker - MINT-Labs projects, since April 2023)
Senninger Antonia - Section Biomed (since July 2023)
Simmler Julia - Section CBB (since November 2022)
Stengel Laura - Section Biomed (since March 2023)
Wolff Ann-Kathrin - Section SBB (since October 2025)
Contact us
If interested please contact us!
Contact: rigel.school@ur.de
Our activities:
2011
Kooperationsvertrag mit Ortenburg-Gymnasium Oberviechtach
2012
Schülerin des Ortenburg-Gymnasiums trifft Nobelpreisträger Robert Huber
2013
Genetik-Praktikum am Ortenburg-Gymnasium Oberviechtach
Schülerlabortag am Donau-Gymnasium in Kelheim
2014
Kooperationsvertrag mit dem Donau-Gymnasium Kelheim
2015
Nacht.Schafft.Wissen. Regensburg
Schülerlabortag am Donau-Gymnasium in Kelheim
2016
Genetik-Praktikum im Werner-von-Siemens Gymnasium Regensburg
Genetik-Praktikum am Gymnasium Neutraubling
Genetik-Praktikum am Donau-Gymnasium Kelheim
2017
Genetik-Praktikum am Donau-Gymnasium Kelheim
Genetik-Praktikum am Gymnasium Neutraubling
Kooperationsvertrag mit dem Johann-Michael-Fischer-Gymnasium Burglengenfeld
2018
Genetik-Praktikum am Donau-Gymnasium Kelheim
Gentik-Praktikum am Johann-Michael-Fischer-Gymnasium Burglengenfeld
Genetik-Praktikum am Gymnasium Neutraubling
2019
Nacht.Schafft.Wissen. Regensburg
Genetik-Praktikum am Donau-Gymnasium Kelheim
Gentik-Praktikum am Johann-Michael-Fischer-Gymnasium Burglengenfeld
Genetik-Praktikum am Gymnasium Neutraubling
2021
Gentik-Praktikum am Johann-Michael-Fischer-Gymnasium Burglengenfeld
2022
Gentik-Praktikum am Johann-Michael-Fischer-Gymnasium Burglengenfeld
Genetik-Praktikum am Donau-Gymnasium Kelheim
Doktoranden Speed-Dating mit Schulklassen in den MINT-Labs Regensburg
Glowing Fish Projekt in den MINT-Labs Regensburg
2023
Glowing Fish Projekt in den MINT-Labs Regensburg
Morphologie und Stoffwechsel der Bäckerhefe Projekt in den MINT-Labs Regensburg
Gentik-Praktikum am Ursulinen Gymnasium Straubing
Gentik-Praktikum am Johann-Michael-Fischer-Gymnasium Burglengenfeld
Genetik-Praktikum am Donau-Gymnasium Kelheim
Info-Veranstaltung zur Studien- und Berufsorientierung am Albrecht Altdorfer-Gymnasium Regensburg
Open-Labs Day MINT-Labs Regensburg
2024
Info-Veranstaltung zur Studien- und Berufsorientierung am Albrecht Altdorfer-Gymnasium Regensburg
Open-Labs Day MINT-Labs Regensburg
Gentik-Praktikum am am Gabelsberger Gymnasium Mainburg
2025
MOBI-Lab am FOS Kelheim
Gentik-Praktikum am Johann-Michael-Fischer-Gymnasium Burglengenfeld
MOBI-Lab Gymnasium Cham
Genetik-Praktikum am Donau-Gymnasium Kelheim
Türen auf mit der Maus - Molekularbiologie


